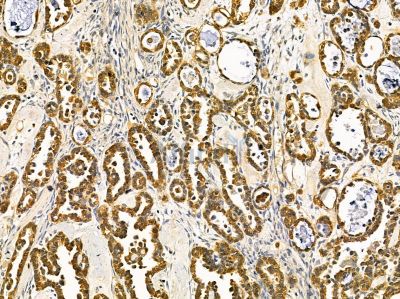
USP4 Antibody - DF14550 at 1/100 staining human ovarian cancer by IHC-P.

USP4 Antibody - #DF14550
Related Downloads
Protocols
Product Info
*The optimal dilutions should be determined by the end user. For optimal experimental results, antibody reuse is not recommended.
*Tips:
WB: For western blot detection of denatured protein samples. IHC: For immunohistochemical detection of paraffin sections (IHC-p) or frozen sections (IHC-f) of tissue samples. IF/ICC: For immunofluorescence detection of cell samples. ELISA(peptide): For ELISA detection of antigenic peptide.
Immunogens
A synthesized peptide derived from human USP4.
Overexpressed in small cell tumors and adenocarcinomas of the lung compared to wild-type lung (at protein level). Expressed in the hippocampal neurons.
- Q13107 UBP4_HUMAN:
- Protein BLAST With
- NCBI/
- ExPASy/
- Uniprot
MAEGGGCRERPDAETQKSELGPLMRTTLQRGAQWYLIDSRWFKQWKKYVGFDSWDMYNVGEHNLFPGPIDNSGLFSDPESQTLKEHLIDELDYVLVPTEAWNKLLNWYGCVEGQQPIVRKVVEHGLFVKHCKVEVYLLELKLCENSDPTNVLSCHFSKADTIATIEKEMRKLFNIPAERETRLWNKYMSNTYEQLSKLDNTVQDAGLYQGQVLVIEPQNEDGTWPRQTLQSKSSTAPSRNFTTSPKSSASPYSSVSASLIANGDSTSTCGMHSSGVSRGGSGFSASYNCQEPPSSHIQPGLCGLGNLGNTCFMNSALQCLSNTAPLTDYFLKDEYEAEINRDNPLGMKGEIAEAYAELIKQMWSGRDAHVAPRMFKTQVGRFAPQFSGYQQQDSQELLAFLLDGLHEDLNRVKKKPYLELKDANGRPDAVVAKEAWENHRLRNDSVIVDTFHGLFKSTLVCPECAKVSVTFDPFCYLTLPLPLKKDRVMEVFLVPADPHCRPTQYRVTVPLMGAVSDLCEALSRLSGIAAENMVVADVYNHRFHKIFQMDEGLNHIMPRDDIFVYEVCSTSVDGSECVTLPVYFRERKSRPSSTSSASALYGQPLLLSVPKHKLTLESLYQAVCDRISRYVKQPLPDEFGSSPLEPGACNGSRNSCEGEDEEEMEHQEEGKEQLSETEGSGEDEPGNDPSETTQKKIKGQPCPKRLFTFSLVNSYGTADINSLAADGKLLKLNSRSTLAMDWDSETRRLYYDEQESEAYEKHVSMLQPQKKKKTTVALRDCIELFTTMETLGEHDPWYCPNCKKHQQATKKFDLWSLPKILVVHLKRFSYNRYWRDKLDTVVEFPIRGLNMSEFVCNLSARPYVYDLIAVSNHYGAMGVGHYTAYAKNKLNGKWYYFDDSNVSLASEDQIVTKAAYVLFYQRRDDEFYKTPSLSSSGSSDGGTRPSSSQQGFGDDEACSMDTN
Research Backgrounds
Deubiquitinating enzyme that removes conjugated ubiquitin from target proteins. Deubiquitinates PDPK1. Deubiquitinates TRIM21. Deubiquitinates receptor ADORA2A which increases the amount of functional receptor at the cell surface. May regulate mRNA splicing through deubiquitination of the U4 spliceosomal protein PRPF3. This may prevent its recognition by the U5 component PRPF8 thereby destabilizing interactions within the U4/U6.U5 snRNP. May also play a role in the regulation of quality control in the ER.
Monoubiquitinated by TRIM21. Ubiquitination does not lead to its proteasomal degradation. Autodeubiquitinated.
Cytoplasm. Nucleus.
Note: Shuttles between the nucleus and cytoplasm. Exported to the cytoplasm in a CRM1-dependent manner and recycled back to the nucleus via the importin alpha/beta heterodimeric import receptor. The relative amounts found in the nucleus and cytoplasm vary according to the cell type.
Overexpressed in small cell tumors and adenocarcinomas of the lung compared to wild-type lung (at protein level). Expressed in the hippocampal neurons.
The DUSP and ubiquitin-like 1 domains promote ubiquitin release and thus enhance USB4 catalytic activity. However, these domains do not bind ubiquitin.
Belongs to the peptidase C19 family. USP4 subfamily.
Restrictive clause
Affinity Biosciences tests all products strictly. Citations are provided as a resource for additional applications that have not been validated by Affinity Biosciences. Please choose the appropriate format for each application and consult Materials and Methods sections for additional details about the use of any product in these publications.
For Research Use Only.
Not for use in diagnostic or therapeutic procedures. Not for resale. Not for distribution without written consent. Affinity Biosciences will not be held responsible for patent infringement or other violations that may occur with the use of our products. Affinity Biosciences, Affinity Biosciences Logo and all other trademarks are the property of Affinity Biosciences LTD.